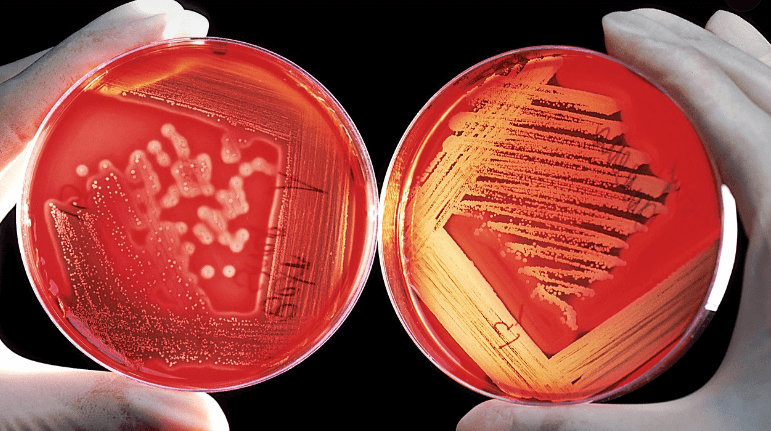
알테오젠-주가-전망-머크매각-알아보기

알테오젠은 국내 대표 제약바이오 기업으로 연구개발에 힘쓰고 있는 기업입니다. 알테오젠은 지속적인 기술이전을 통해 해외 빅파마들과 협업을 해오고 있습니다. 이 글을 통해 알테오젠 주가, 전망, 머크 매각에 대해 알아보도록 하겠습니다.

목차
1. 알테오젠 주가
2. 알테오젠 주가전망
3. 알테오젠 머크매각
4. 알테오젠 기업분석
1. 알테오젠 주가
바이오의약품 관련주 알테오젠은 코로나 창궐 직후 다른 바이오 기업들과 함께 바이오산업이 관심을 받으며 주가가 크게 상승하였습니다. 이후 기술이전의 소식이 전해질 때마다 주가가 상승하긴 하였지만 전체적으로는 우하향 추세를 벗어나지 못하고 있습니다.

2020년 3월 19일 ~ 2020년 9월 02일
- 코로나 충격으로 인해 15,325원까지 하락
- 코로나 백신, 치료제 기대감으로 제약바이오 기업의 주가 상승
- 2020년 9월 02일까지 단기간 상승(126,786원)
- 기술이전 기대감이 반영되며 상승
[주식 초고수는 지금] 알테오젠, 美 머크와의 협업 기대감에 매수 1위
미래에셋증권(006800)에서 거래하는 고수익 투자자들이 24일 오전 가장 많이 순매수한 종목은 알테오젠(196170)으로 나타났다. 유진투자증권(001200), 한미반도체(042700), LIG넥스원(079550)
n.news.naver.com
2020년 3월 19일 ~ 2022년 10월 13일
- 2020년 9월 2일 126,786원을 고점으로 지속 하락하여 27,901원까지 하락
- 지속적인 실적 악화로 인한 하락
- 코로나 이슈 소멸로 인한 하락
- 금리 인상으로 인해 성장주 대표주자인 바이오기업 주가 하락
2022년 10월 13일 ~ 현재
- 저점을 다지고 상승추세 6만 원 중반까지 회복
- 금리 인하 기대감으로 인한 상승
- 머크로의 인수로 인한 기대감
- 실적의 개선으로 역대 최대인 650억 원의 매출액 예상
- 영업이익 개선(전년: -294억, 올해: -20억)
2. 알테오젠 주가전망
알테오젠은 다른 바이오 기업들과 같이 주가의 예측이 쉽지 않습니다. 임상, 기술이전 등 변수가 많아 투자에 어려움이 있습니다. 하지만 알테오젠은 이미 세계 유수의 빅파마들과 기술이전 경험이 있어 기술력을 인정받은 기업입니다. 알테오젠 주가는 기술이전, 임상성공 등의 뚜렷한 성과가 기대되거나, 최근 이슈가 붉어지고 있는 머크사로의 매각 이슈에 따라 주가가 움직일 것으로 보여 관련 뉴스 flow를 잘 살펴보아야 할 것으로 생각됩니다.
3. 알테오젠 머크매각
[단독] 알테오젠, 글로벌 빅파마 머크에 매각 임박
이 기사는 2023년09월19일 10시56분에 팜이데일리 프리미엄 콘텐츠로 선공개 되었습니다. 시총 3조원대 국내 바이오 기업 알테오젠(196170)이 글로벌 빅파마 머크(MSD)와 매각 협상을 진행 중인 것으로
n.news.naver.com
알테오젠은 최근 세계 최고 수준의 기업인 머크(MSD)와의 매각설이 나오며 관심을 받고 있습니다. 알테오젠 관계자는 최근 주주총회에서 머크와 M&A이슈에 대해 이야기하였습니다. 하지만 정확한 답변이 아닌 최대주주의 의중에 따라 결정될 것이라는 것만 발표하며 더욱더 궁금증을 자아냈습니다. 알테오젠은 회사의 매각 외에도 MSD사와 ALT-B4에 대한 독점 계약에 대해 논의 중에 있습니다. 알테오젠과 머크(MSD)는 2020년부터 ALT-B4 원천기술에 대한 기술 이전 계약에 서명하고 개발에 힘쓰고 있습니다. 향후 머크에 매각이 이루어지는지 지속해서 관심을 가지고 살펴볼 필요가 있을 것으로 보입니다.
4. 알테오젠 기업분석
제약바이오 관련주 알테오젠은 2008년 5월 설립되어 바이오의약품을 개발하고 생산, 판매하기 위해 설립된 기업입니다. 당사는 자본금을 확충하기 위해 2014년 기술성장기업 특례를 통해 상상하여 자본금을 모았습니다. 당사는 이러한 자본금을 통해 히알루로니다아제 기반기술을 개발하여 해외 유수의 기업들과 기술수출의 성과를 거두고 있습니다. 알테오젠은 테르가제주, 아일리아 등 다양한 의약품들을 개발하고 있으며, 바이오시밀러인 ALT-L9는 12개 나라에 임상 3상 시험을 진행하며 결과를 기다리고 있습니다. 또한 알테오젠은 지금까지의 업력을 활용하여 타 기업들과 공공연구, 위탁생산 등의 업무를 수행하기 위해 노력하고 있습니다.
셀트리온주가 배당금
셀트리온은 셀트리온헬스케어, 셀트리온제약의 합병이슈가 불거지며 주주들이 관심을 갖고 바라보고 있습니다. 이 글을 통해 셀트리온합병 이슈와 주가 배당 등 다양한 정보를 알아보도록 하
ecsj.co.kr

이상으로 최근 글로벌 제약사인 머크와 매각 이슈가 있는 알테오젠의 주가, 전망에 대해 알아보았습니다.
'기업 > 제약바이오' 카테고리의 다른 글
| 인터로조 주가 전망 배당금 알아보기 (0) | 2023.12.19 |
|---|---|
| 셀트리온헬스케어 주가 전망 배당금 알아보기 (0) | 2023.12.15 |
| HLB 주가 전망 기업분석 알아보기 (0) | 2023.11.23 |
| 현대바이오 주가 전망 코로나치료제 관련주 (0) | 2023.11.21 |
| 셀트리온주가 배당금 (0) | 2023.11.02 |

